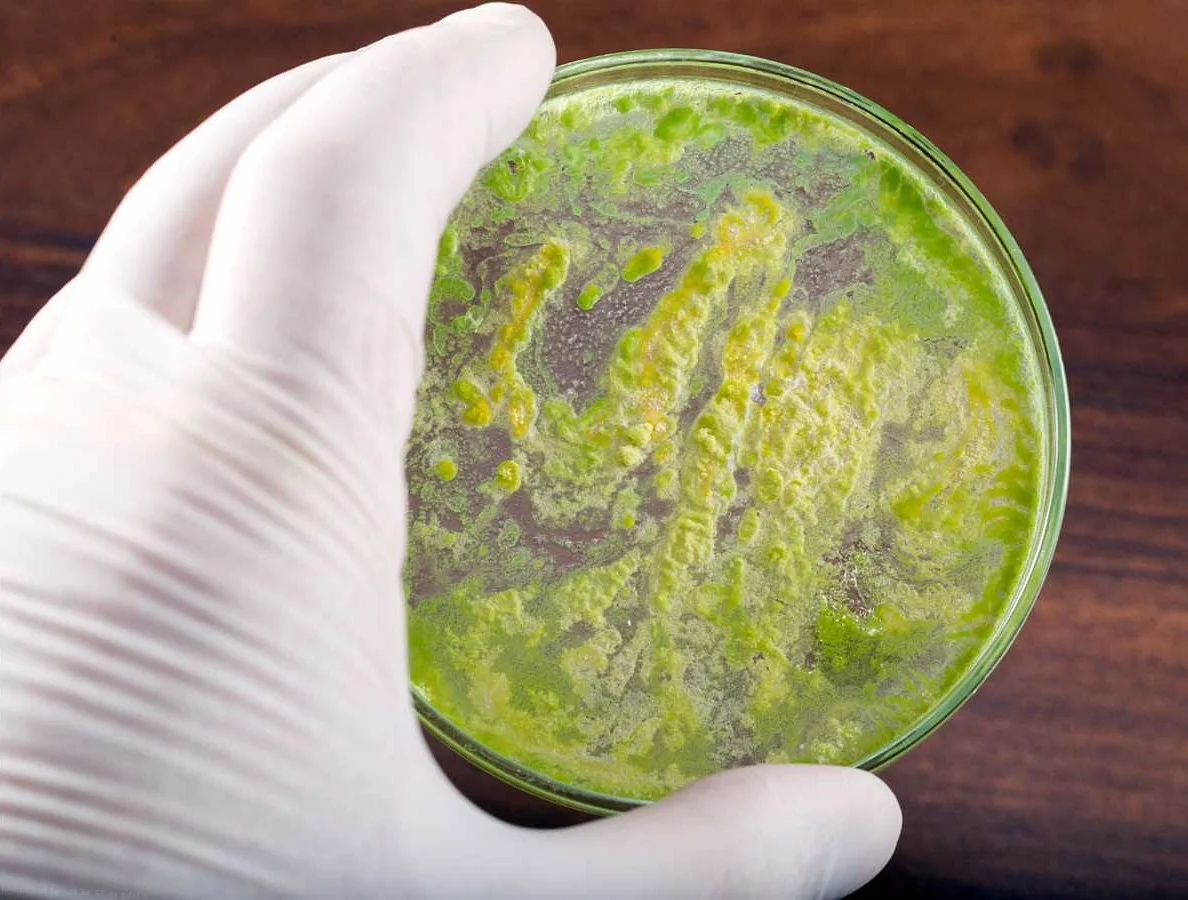

Лечение энтерококковых инфекций

Лечение энтерококковых инфекций обычно включает применение антибиотиков и поддерживающую терапию. Выбор антибиотика зависит от чувствительности энтерококков к препаратам, поэтому перед началом лечения проводится бактериологический анализ и определение чувствительности микроорганизмов к антибиотикам.
Одним из основных антибиотиков, используемых для лечения энтерококковых инфекций, является ванкомицин. Этот препарат эффективен против большинства штаммов энтерококков, однако некоторые штаммы могут быть устойчивыми к нему.
В случае устойчивости к ванкомицину или при высокой степени тяжести инфекции может быть назначен линезолид. Он также активен против энтерококков, в том числе и устойчивых к ванкомицину.
Помимо антибиотиков, может быть назначена симптоматическая терапия, направленная на снятие симптомов инфекции. Это может включать прием жидкостей, противовоспалительных препаратов для снижения температуры и облегчения боли, а также препаратов для поддержания функции органов и систем организма.
Основными принципами лечения энтерококковых инфекций являются своевременная диагностика, подбор антибиотиков с учетом чувствительности микроорганизмов, а также их правильное применение и соблюдение рекомендаций врача. Кроме того, важным моментом является профилактика энтерококковых инфекций, особенно в медицинских учреждениях, где возможно передача инфекции от пациента к пациенту. Соблюдение правил личной гигиены и антисептических мероприятий помогает предотвратить распространение энтерококковых инфекций.
ПрепаратДозировкаПобочные эффекты
| Ванкомицин | Дозировка зависит от вида и тяжести инфекции | Возможны аллергические реакции, нарушение функции почек и кишечника |
| Линезолид | 600 мг дважды в сутки | Может вызывать диспептические расстройства, анемию, тромбоцитопению |
Методы выявления и норма
В норме энтерококки в кале у ребенка до года должны содержаться в количестве от 105 до 107. После года эта цифра может увеличиться до 105-108.
Если же обнаружен энтерококк в моче в количестве 10 в 3 степени, значит, возможно воспаление органов мочеполовой системы. Такое состояние бывает вызвано следующими факторами:
- прием антибиотиков;
- употребление наркотических препаратов;
- общее снижение резистентности организма;
- частые спринцевания, приводящие к нарушению баланса микрофлоры влагалища;
- механическое попадание фекального энтерококка из анального отверстия во влагалище;
- анальный секс;
- недостаточное соблюдение гигиены половых органов как у женщин, так и у мужчин;
- гормональные изменения;
- беременность.
Если в мазке из влагалища обнаружен Enterococcus faecalis 10 во 2 степени, это может свидетельствовать о нарушении техники взятия материала, когда бактерия попадает в половые органы из прямой кишки.
Повышенное количество энтерококков, составляющее 10 в 5 степени и более, свидетельствует об их активном размножении и проявляется следующими клиническими признаками:
- зуд;
- ноющие боли в нижней части живота;
- давящие интенсивные боли в пояснице;
- сероватые или серо-коричневые вагинальные выделения;
- учащенное и болезненное мочеиспускание.
Обнаруженные в большом количестве энтерококки в мазке из уретры у мужчин указывают на воспаление. Чаще всего оно провоцируется инструментальными исследованиями или установкой катетера при невозможности естественного отхождения мочи.
Для выявления количественного состава микрофлоры половых органов у мужчин и женщин делают бакпосев. Наличие Enterococcus faecalis в титре 10^4 КОЕ/мл значит, что содержание бактерий не превышает допустимые нормы и не требует применения антибиотиков.
Увеличение титра Enterococcus faecalis до 10^6 КОЕ/тамп на первых этапах развития заболеваний может не проявляться клинически и обнаружиться случайно во время планового медицинского обследования.
Фекальный энтерококк стоит на одном из первых мест в списке причин возникновения хронического простатита. Наличие Enterococcus faecalis в секрете предстательной железы выявляют при помощи следующих методов:
- гистологический анализ тканей простаты (биопсия);
- полимеразная цепная реакция;
- посев секрета предстательной железы на питательные среды для выявления чувствительности к антибиотикам;
- иммунофлуоресцентный анализ.
Количество энтерококков Enterococcus faecalis при проведении спермограммы в норме у мужчин не превышает 105.
У маленьких детей энтерококкус фекалис может находиться во рту, попадая туда при сосании груди матери, недостаточно заботящейся о гигиене молочных желез. Если у ребенка при посеве выделили микрофлору Enterococcus faecalis, то это свидетельствует о наличии в ротовой полости или в горле раневой поверхности, на которой активно размножается энтерококк.
Причины появления энтерококков
Энтерококки распространяются в кишечной микрофлоре с момента рождения младенца. Изначально они могут проникать в организм ребёнка воздушно-капельным способом. Присутствуют они также и в грудном молоке, откуда попадают в кишечник малыша с первым кормлением. Само наличие бактерий является нормальным, но патологические процессы могут начать развиваться, когда количество энтерококков повышается.
Важно! Норма содержания Enterocоccus в кале младенца возрастом до 1 года – от 100000 до 10000000 в 1 грамме кала. Причины повышения энтерококков:
Причины повышения энтерококков:
- простудные заболевания;
- длительное применение антибиотиков;
- инвазивные способы медицинской диагностики;
- неблагоприятные условия окружающей среды;
- ранний переход на адаптированные смеси;
- введение прикорма ранее рекомендуемых сроков.
Уровень энтерококков может быть и низким относительно нормы, по причине физиологии отдельного организма, но это не оказывает негативного влияния на здоровье и не должно лечиться.
Профилактика
Профилактические мероприятия направлены на укрепление иммунитета, правильное питание, отказ от вредных привычек, ведение активного образа жизни, занятия спортом, закаливание.
Специалисты рекомендуют:
- Соблюдать правила личной гигиены – мыть с мылом руки перед едой и после посещения общественных мест.
- Употреблять в пищу полезные продукты.
- Избегать конфликтных ситуаций и эмоционально не напрягаться.
- Защищать организм от переохлаждения.
- Соблюдать режим труда и отдыха.
- Высыпаться.
- Не принимать бесконтрольно антибиотики и любые другие препараты.
- Увеличить двигательную активность.
- Своевременно лечить имеющиеся хронические болезни.
Энтерококки при беременности и у грудных детей
Обнаружение энтерококка в моче при беременности свидетельствует о воспалительном процессе в органах мочеполовой системы женщины. Несвоевременно проведенное лечение может привести к инфицированию плода, его замиранию, выкидышу или преждевременным родам.
Enterococcus faecalis в моче при беременности развивается благодаря созданию благоприятных условий за счет гормональных изменений, снижения резистентности организма, отсутствия достаточной личной гигиены. Инфекция может распространиться по лимфатическим путям из пораженного кишечника.
Перед разработкой схемы лечения фекального энтерококка врач обязательно назначает повторное обследование. Ведь энтерококки в мазках при беременности могли быть обнаружены ошибочно из-за неправильного забора материала или попадания микроба во влагалище из заднего прохода.
Обнаружение повышенного содержания энтерококков в кале у ребенка свидетельствует о наличии патологических процессов, которые проявляются следующими симптомами:
- диарея;
- частые приступы плача, беспокойство;
- отказ от пищи;
- метеоризм;
- зловонный запах каловых масс.
Энтерококки у грудничка в кале могут появиться в результате несоблюдения правил гигиены во время ухода, а также при попадании микробов с материнским молоком. Своевременно проведенное лечение бактериофагами приводит к быстрому восстановлению микрофлоры кишечника и исчезновению клинических признаков заболевания.
Восстановление после лечения Enterococcus faecalis: что нужно знать?
Enterococcus faecalis — бактерия, которая может вызвать серьезные заболевания у человека. Лечение этой бактерии может быть длительным и сложным процессом, который требует от пациента множественных курсов антибиотиков. Но что же делать после того, как бактерия уже была выведена из организма?
Специалисты рекомендуют пациентам, которые проходили лечение от Enterococcus faecalis, следовать нескольким основным правилам, чтобы помочь своему организму восстановиться. В первую очередь, необходимо строго соблюдать рекомендации врача, которые касаются приема лекарств и процедур. Кроме того, следует вести здоровый образ жизни: правильное питание, заниматься спортом, избегать плохих привычек и соблюдать режим дня.
После лечения Enterococcus faecalis важно также придерживаться правил личной гигиены. Регулярное мытье рук, чистка зубов и использование антисептических средств не только помогут восстановиться после болезни, но и предотвратят возможность повторного заражения бактерией
Кроме того, защитите свой иммунитет: осенью и зимой, когда организм особенно подвержен вирусным и бактериальным инфекциям, необходимо укреплять свой организм витаминами и минералами.
- Несколько советов по восстановлению после Enterococcus faecalis:
- Кушайте пищу, богатую пробиотиками;
- Увеличьте время проведенное на свежем воздухе;
- Ограничьте употребление сахара в своей диете;
- Пейте больше воды و избегайте алкоголя;
- Убедитесь, что вы получаете достаточно сна;
- Посетите психолога или психотерапевта, если у вас есть проблемы со стрессом или паникой после болезни;
Не стоит забывать, что восстановление после лечения Enterococcus faecalis может занять некоторое время. Всеобщее состояние здоровья постепенно улучшится, если вы будете соблюдать все необходимые рекомендации и ухаживать за своим организмом.
Как правильно сдавать анализ кала на дисбактериоз?
Диета и отмена медикаментов – это первичные условия достоверности результатов анализа. Кроме того, пациенту потребуется собрать кал в соответствие с правилами.
Сдаем кал – 6 правил:
- Перед контрольной дефекацией вымыть промежность (исключается вероятность попадания застарелых образцов).
- Запрещено использование любых вспомогательных средств для ускорения процесса дефекации (клизма, слабительное).
- Заранее подготавливают специальный контейнер с плотной крышкой (нужно приобрести в аптеке).
- Нельзя допустить попадание жидкости в кал (моча, вода и др.).
- Взять 3 фрагмента кала (по 1 чайной ложке из разных участков).
- Если присутствует кровь или слизь, то такие образцы берут в обязательном порядке.
Бактерии кишечника в основном анаэробные. Через 1 час после дефекации они еще будут сохранять свою популяцию в естественном виде, однако постепенно микроорганизмы начнут гибнуть.
Чтобы правильно сдать анализ кала на дисбактериоз, необходимо доставить образцы экскрементов в лабораторию хотя бы в течение 2 часов после опорожнения.
Срочность не столь существенна для биохимического исследования, которое изучает не колонии бактерий, а результат их жизнедеятельности – жирные кислоты. Эти соединения самопроизвольно почти не распадаются, поэтому и сохраняются в неизменном виде достаточно долго.
Врачи разрешают даже заморозить кал и привести его на следующий день. В случае с новорожденными детьми такой вариант иногда самый предпочтительный для родителей.
В кишечнике обитает 100 триллионов бактерий, что в 10 раз больше количества всех клеток организма. Если микробов не будет совсем, то человек попросту скончается.
С другой стороны, смещение баланса в любую сторону приводит к заболеваниям. Расшифровка анализа кала на дисбактериоз заключается в определении численности и типов микробов.
Таблица расшифровки результатов и норм анализа
| Дети до 1 года | Дети старшего возраста | Взрослые | |
| Бифидобактерии | 10 10 – 10 11 | 10 9 – 10 10 | 10 8 – 10 10 |
| Лактобактерии | 10 6 – 10 7 | 10 7 – 10 8 | 10 6 – 10 8 |
| Эшерихии | 10 6 – 10 7 | 10 7 – 10 8 | 10 6 – 10 8 |
| Бактероиды | 10 7 – 10 8 | 10 7 – 10 8 | 10 7 – 10 8 |
| Пептострептококки | 10 3 – 10 5 | 10 5 – 10 6 | 10 5 – 10 6 |
| Энтерококки | 10 5 – 10 7 | 10 5 – 10 8 | 10 5 – 10 8 |
| Сапрофитные стафилококки | ≤10 4 | ≤10 4 | ≤10 4 |
| Патогенные стафилококки | – | – | – |
| Клостридии | ≤10 3 | ≤10 5 | ≤10 5 |
| Кандида | ≤10 3 | ≤10 4 | ≤10 4 |
| Патогенные энтеробактерии | – | – | – |
Подробная расшифровка:
1. Бифидобактерии:
- 95% от всех бактерий, обитающих в кишечнике;
- синтезируют витамины К и В;
- способствуют усвоению витамина D и кальция;
- укрепляют иммунитет.
2. Лактобактерии:
- поддерживают кислотность;
- синтезируют лактазу и защитные вещества.
3. Эшерихии:
- синтезируют витамины К и В;
- способствуют усвоению сахаров;
- производят колицины – белки, убивающие микробов.
4. Бактероиды:
- расщепляют жиры;
- выполняют защитную функцию.
5. Стрептококки:
- расщепляют углеводы;
- выполняют защитную функцию;
- присутствуют в малых количествах и не всегда.
6. Энтерококки:
расщепляют углеводы.
7. Пептококки:
- участвуют в синтезе жирных кислот;
- выполняют защитную функцию;
- присутствуют не всегда.
8. Стафилококки:
- обитают в толстом кишечнике;
- участвуют в нитратном обмене;
- существует множество патогенных штаммов.
9. Клостридии:
- обитают в толстом кишечнике;
- синтезируют кислоты и спирты;
- расщепляют белки.
10. Грибковые:
- поддерживают кислую среду;
- условно-патогенные.
Изменение численности тех или иных микроорганизмов возможно при попадании в кишечник болезнетворных штаммов.
Обычно это происходит при несоблюдении личной гигиены (грязные руки, немытые фрукты и овощи). Лечение антибиотиками – вторая распространенная причина дисбактериоза.
К тому же дисбактериоз нередко свидетельствует об иммунном сбое. Лейкоциты контролируют популяцию микробов, численность которой при снижении естественной защиты существенно увеличивается. И зачастую размножаются не полезные бактерии, а патогенные.
Эффективны ли альтернативные методы лечения Enterococcus faecalis: мнение экспертов?

Enterococcus faecalis — один из видов Enterococcus, которые могут вызывать различные инфекции у человека. Часто они являются возбудителями развития осложнений при больницах и других медицинских учреждениях. Как правило, данный вид бактерий достаточно устойчив к антибиотикам, что может затруднять процесс лечения.
Некоторые эксперты утверждают, что альтернативные методы терапии могут помочь в борьбе с Enterococcus faecalis. Одним из таких методов является использование пробиотиков. Они могут повысить иммунитет человека и дополнительно защитить его от вредных бактерий, в том числе и Enterococcus faecalis.
Кроме того, некоторые исследования указывают на эффективность некоторых растительных экстрактов, например, чеснока и лайма, в борьбе с данным видом бактерий. Однако, большинство экспертов придерживается мнения, что только курс антибиотиков, назначенный врачом, может гарантировать полное излечение от инфекции Enterococcus faecalis.
Таким образом, альтернативные методы могут оказаться дополнительными инструментами в борьбе с Enterococcus faecalis, но только комплексное лечение, под контролем профессионалов, может гарантировать успех.
Кровь в кале
Появление даже небольшого количества крови в выделениях малыша должно вызвать беспокойство у родителей. Этот признак представляет серьезную опасность для здоровья ребенка.
Кровь в кале может свидетельствовать о различных заболеваниях:
- Обнаружение крови на туалетной бумаге может быть явным признаком геморроя или трещин в области анального отверстия;
- Прожилки крови в дефекации могут указывать на симптомы язвенного колита, рака прямой кишки или болезни Крона;
- Наличие крови со слизью может свидетельствовать о проктите, полипах или язвенных очагах;
- Жидкий стул с кровью может свидетельствовать о наличии инфекции в кишечнике.
Особенности терапии
Лечение во многом зависит от того, какие именно микроорганизмы отклонились от нормы, присутствует ли в кале слизь, кровь и другие частицы, которых быть не должно. Врач, изучая результаты, диагноз ставит не раньше, чем проанализирует все показатели.
Если расшифровка показывает снижение количества кишечной палочки, это может говорить о наличии в кишечнике глистов. Иногда причиной может быть снижение ферментативной активности, из-за чего пользы эта бактерия не приносит (хоть и не вредит). Несмотря на всю пользу кишечной палочки, её число не должно превышать норму. Если это случилось, значит, в организме развивается дисбактериоз.
Что касается гемолитических кишечных палочек, то у маленьких детей они должны отсутствовать вообще. Эти патогены производят токсины, которые негативно воздействуют на нервную систему и кишечник, а также способны вызвать различные кишечные болезни, аллергию.
Дефицит бифидобактерий, бактероидов приводит к длительным кишечным нарушениям как у детей, так и у взрослых. Эти бактерии появляются у малыша на десятый день жизни. При этом у детей, которые родились через кесарево сечение их значительно меньше, чем у малышей, появившихся природным путем.
Лактозонегативные энтеробактерии у детей и взрослых не должны превышать нормы. Если анализ показывает их повышенную пролиферацию, этим можно объяснять наличие у малыша изжоги, срыгивания, отрыжки, повышенного газообразования. Энтерококки в норме организму не вредят и даже полезны. Но если их число выше нормы, они станут причиной развития инфекционных болезней органов малого таза, мочевыводящих путей.
Тогда как непатогенные стафилококки организму особо не вредят (в пределах нормы), наличие золотистого стафилококка для детей опасно. Он вызывает у малыша понос, рвоту, боль в животе, высокую температуру, в кале присутствует слизь, кровь. Поэтому в кале грудничков золотистый стафилококк должен отсутствовать. Если же золотистый стафилококк в организме присутствует, то его действие зависит от полезных бактерий
. Если их число будет в норме, организму золотистый стафилококк не страшен и кроха в лечении не нуждается. В тяжелом случае нужна госпитализация.
Когда врач назначит лечение, его указания нужно соблюдать обязательно. Чтобы уничтожить грибок, клостридии, клебсиеллы, лактозонегативные энтеробактерии, золотистый стафилококк, привести в норму систему пищеварения, избавиться от слизи в кале, необходимы специальные лекарства, рассчитанные на маленьких деток.
Особое внимание во время лечения нужно обратить на питание детей, поскольку во многих случаях именно неправильно подобранный рацион становится причиной роста клостридий, энтеробактерий, клебсиелл и других патогенов. Диету требуется согласовать с врачом
Если малыш находится на грудном вскармливании, диету обязана соблюдать мама.
Анализ кала на дисбактериоз является популярным исследованием, которое требует соблюдения определенных правил при сборе и транспортировке материала. Именно он является поводом для начала лечения заболевания, существование которого не признается мировой медициной. Что же показывает этот анализ?
Что это такое
Йодофильная флора представляет собой совокупность бактерий, способных превращать крахмал в глюкозу и определенные кислоты. Выделяемые ферменты запускают процесс брожения в кишечнике. Способствует размножению подобных микроорганизмов употребление детьми большого количества углеводов.
Микрофлору кишечника составляют:
- полезные бактерии;
- условно-патогенные микроорганизмы.
Только за счет преобладания полезной флоры ребенок чувствует себя здоровым, а вредоносные микроорганизмы не имеют возможности размножаться и вызывать различные воспаления.
В копрограмме допускается наличие мизерного количества йодофильной флоры. Чем меньше, тем лучше
Постановка диагноза по полученной доктором расшифровке происходит с обязательным вниманием на сопутствующие симптомы или результаты дополнительных обследований
Какие бактерии учитываются в анализе?
Что это?
Анализ на дисбактериоз представляет собой лабораторное исследование, с помощью которого можно примерно определить состав кишечной микрофлоры. Поскольку проблемы с перевариванием пищи и всасыванием из нее полезных веществ могут служить поводом для появления различных отклонений, посев кала на дисбактериоз может назначаться при наличии:
- расстройств стула;
- подозрений на ;
- чувства дискомфорта в животе;
- аллергических реакций;
- непереносимости определенных продуктов питания;
- высыпаний на коже.
Кал на дисбактериоз сдают для определения характера нарушений биоценоза кишечника по наличию и количеству:
- лактобактерий;
- грибков;
- энтеробактерий;
- клостридий;
- сальмонелл;
- шигелл;
- дизентерийной палочки и прочих патогенных микроорганизмов.
Виды
Анализ на дисбактериоз может проводиться в специализированных бактериологических или многопрофильных лабораториях двумя методами:

Кроме исследований кала на микробиологический состав, всем пациентам без исключения с подозрениями на дисбактериоз назначают копроскопию. В ходе ее оценивается внешний вид каловых масс, так как цвет кала при дисбактериозе обычно меняется и становится несколько зеленоватым. Но основной целью этого анализа является выявление в фекалиях:
Расшифровка анализа кала на дисбактериоз является задачей лечащего врача. Для каждой возрастной категории пациентов существуют свои нормы анализа на дисбактериоз. Они представлены в широком доступе, поэтому предварительно оценить свои результаты каждый может самостоятельно.
Примерно так выглядит бланк с результатами исследования
Проводя диагностику дисбактериоза кишечника, нужно учитывать, что на результаты исследования существенное влияние оказывают такие факторы, как:
- Контакт с воздухом. В составе кишечной микрофлоры всегда присутствуют анаэробные микроорганизмы, то есть те, для жизнедеятельности которых не требуется кислород, причем контакт с воздухом может быть даже губительным для них. Поскольку собрать кал так, чтобы полностью воспрепятствовать контакту с воздухом, не удастся, нужно понимать, что реальное количество анаэробов различных видов в кишечнике больше, чем показывают анализы, а величина этой разницы зависит от скорости сбора материала и видового состава микрофлоры.
- Время между сбором и проведением анализа. Информативность исследования снижается прямо пропорционально количеству времени, прошедшему между сбором материала и проведением анализа, поскольку часть содержащихся в нем микроорганизмов гибнет.
- Исследование кала на дисбактериоз дает представление исключительно о составе микрофлоры, находящейся в просвете кишечника, но оно практически не дает информации о микроорганизмах, обитающих на его стенках. Хотя именно пристеночные бактерии и являются предметом интереса гастроэнтерологов, ведь они отвечают за качество пищеварения и всасывание веществ из пищи.
Таким образом, анализ кала дает лишь примерную информацию о составе кишечной микрофлоры.
Кратко о важности борьбы с энтерококковой инфекцией
Диагностика энтерококковой инфекции включает анализы мочи, крови и других биологических материалов на наличие бактерий. Если инфекция подтверждается, необходимо незамедлительно начать лечение антибиотиками, которые эффективно уничтожают энтерококки.
Борьба с энтерококковой инфекцией включает профилактические меры, такие как соблюдение личной гигиены, правильное приготовление пищи, использование антисептических средств и дезинфекция поверхностей
Важно также предотвращать распространение инфекции в медицинских учреждениях через строгое соблюдение стандартных процедур
Обнаружение и своевременное лечение энтерококковой инфекции играют важную роль в сохранении здоровья и предотвращении развития осложнений. Это помогает защитить людей с ослабленным иммунитетом от серьезных последствий, а также предотвращает распространение инфекции среди населения.
Количество и консистенция кала

У новорожденного малыша в течение суток может наблюдаться выделение примерно 20 граммов каловых масс, а у ребенка от 6 месяцев до года – от 100 до 250 грамм. Частота дефекации зависит от скорости роста и изменений в рационе, а также от перехода на обычное взрослое питание.
Существуют и другие причины увеличения количества кала:
- воспаление поджелудочной железы;
- неправильное функционирование пищеварительной системы;
- нарушение работы желудка. Появление диареи;
- проблемы с выделением желчи.
У младенца он текучий, плотный, поскольку в этом возрасте он употребляет исключительно грудное молоко. Когда он становится более густым, это указывает на то, что ребенок начал есть твердую пищу.
Цвет кала и его запах

Обычно у взрослых коричневый цвет кала считается нормой. Однако у младенцев и маленьких детей цвет стула может отличаться.
Что означает цвет кала у ребенка? Как понять, что делать, если он изменился:
- черный. Это может быть признаком кровотечения в желудочно-кишечном тракте;
- коричневый. Указывает на колиты, запоры, употребление белка, растительной пищи;
- красный. При очаговых поражениях желудка;
- зеленоватый. Детское питание с овощными ингредиентами;
- светло-желтый. В период грудного вскармливания;
- белый стул. Проблемы с печенью, двенадцатиперстной кишкой, желтуха.
В детском возрасте часто наблюдается значительное отклонение цвета стула от желтого или золотистого оттенка
В этом случае важно внимательно изучить питание малыша, особенно если он на искусственном кормлении с добавками
Опасность, которую несут энтерококки
Если количество энтерококков в мазке превышает норму, то это свидетельствует об снижении иммунитета. В ослабленном организме патогенность этих бактерий стремительно растет, они быстро размножаются и распространяются по всему телу. Наличие энтерококков в вагинальном или урогенитальном мазке провоцируют появление воспаления в мочеполовой системе.
Они могут формировать новые очаги инфекции, вызывая развитие таких тяжелых заболеваний:
- инфекции мочевыводящих путей (цистит, пиелонефрит, уретрит и др.);
- бактериемию — наличие энтерококков в крови в большом количестве;
- эндокардит — воспаление внутренней оболочки сердца (эндокарда);
- инфекции желудочно-кишечного тракта и различные заболевания органов таза;
- раневые инфекции.
Быстрое увеличение энтерококков приводит к уменьшению полезных бактерий, которые отвечают за местный иммунитет внутрибрюшной области и вагинальной сферы. Поэтому снижение численности полезных бактерий приводит к развитию инфекций и воспалений.
Симптомы
Установить самостоятельно, что возбудителем инфекции является какая-то энтеробактерия, невозможно. Поэтому всегда нужно обращаться к педиатру, если состояние малыша изменилось
Обращать внимание нужно на такие признаки:
- беспокойство и постоянный плач;
- отказ от еды;
- частый стул или запор;
- изменение характера испражнений – водянистые, зловонные, примесь слизи, крови или зелени;
- повышение температуры тела;
- плач при мочеиспускании;
- изменение запаха мочи;
- рвота и тошнота;
- покраснение глаз;
- затрудненное дыхание или кашель;
- снижение общей активности;
- чрезмерная сонливость или долгое возбуждение.
Основные виды и заболевания у малышей
Тот факт, что клебсиелла обнаружена у грудничка в кале, еще не указывает на наличие болезни, и лечить малыша не нужно. К терапии необходимо прибегать, если есть симптомы клебсиеллеза дыхательных путей или кишечника. Часто активизация бактерии приводит к заболеваниям желудка и кишечника. Их признаки схожи с симптомами дисбактериоза:
- вздутие живота и метеоризм, который взывает сильную боль;
- проблемы с дефекацией (присутствие частей пищи в кале, частые позывы, жидкая консистенция, примеси слизи или крови, зеленый цвет, гнилостный запах);
- рвота;
- обильные срыгивания;
- повышение температуры;
- капризность и слабость;
- потеря аппетита.
Существует несколько видов клебсиелл:
- klebsiella rhinoscleromatis (риносклеромы);
- klebsiella ozaenae (озена);
- klebsiella terrigena;
- klebsiella pneumoniae (пневмонии);
- klebsiella planticola;
- klebsiella ornithinolytica;
- klebsiella oxytoca (окситока).
В зависимости от развития иммунитета бактерия способна стать возбудителем инфекционных заболеваний, протекающих в легкой форме. Но если у малыша сильно ослабленный иммунитет или палочку выявили поздно, могут возникнуть тяжелые недуги, которые потребуют срочного вмешательства врачей. Бактерия клебсиелла у ребенка может спровоцировать такие болезни:
- конъюнктивит;
- менингит;
- пневмонию;
- кишечные инфекции;
- гайморит.
Клебсиелла окситока у грудничка
Протекание инфекционных болезней, которые вызваны клебсиеллой окситока, может проходить в тяжелой форме. У новорожденных инфекция вызывает стремительное распространение микробов по всему организму, нередко вызывая поражение мочевыводящей системы или кишечника. Часто клебсиелла в кале ребенка сопровождается стафилококком, который вызывает дисбактериоз и фарингит. Симптомы окситока часто похожи на гастроэнтерит или энтероколит:
- повышение температуры;
- кашель с обильной мокротой;
- вялость;
- частое срыгивание или рвота;
- быстрое снижение веса;
- бледность кожных покровов;
- сильный понос зеленого цвета;
- потеря аппетита;
- цианоз губ;
- наличие синяков под глазами.
Клепсиеллезная пневмония — палочка Фридлендера
Основным местом обитания анаэробной бактерии пневмонии у ребенка является ЖКТ. Болезнь способна протекать тяжело, поэтому требуется обязательная госпитализация. Врачи при этом должны назначить ряд лабораторных исследований. Критическим показателем клебсиеллы в кале у грудничка является содержание, которое превышает 105 клеток бактерии на 1 грамм биоматериала. Симптоматика болезни напоминает пневмококковую инфекцию:
- понос;
- рвота;
- кашель с кровянистой мокротой;
- подъем температуры;
- отказ от груди;
- влажный хрип.
Лечение
За последние 30 лет энтерококки стали устойчивы практически ко всем известным классам антибиотиков. Несмотря на это подобные препараты являются одними из основных для лечения патологии.
Чтобы уменьшить риск развития резистентности используются комбинации различных противомикробных препаратов. Дополнительно проводится посев, чтобы определить степень чувствительности штамма энтерококка к тому или иному препарату.
Чаще всего при легком течении патологии применяются аминогликозиды. Дополнительно могут быть назначены иммуномодуляторы. Способствующие восстановлению защитных свойств организма.
Полезные энтерококки позволяют справляться с патогенной микрофлорой. Поэтому они продаются в форме специальных средств. Пробиотики предназначены для лечения дисбактериоза, восстановления нормальной микрофлоры ЖКТ.
Популярными и известными средствами являются Бифиформ, Линекс. Для создания таких препаратов чаще используют штаммы, которые были селекционированные для пищевой промышленности. Такие штаммы не рассчитаны на слишком длительный период нахождения в организме.
При слишком большом росте энтерококков применяется жидкий бактериофаг. Его можно давать детям первых месяцев жизни. Бактериофаг можно пить или использовать для клизмы.
В заключение отметим, что поддерживать нормальный рост микрофлоры в кишечнике просто, если соблюдать правильный режим питания, совершать прогулки на свежем воздухе.
Врачи напоминают, что вредные привычки снижают защитные силы организма. Поэтому рекомендуется отказаться от них, сделать упор на регулярных видах спорта и закаливания
Особое внимание уделяется грудничкам. У них иммунитет еще сформирован не до конца, поэтому нужно следить за их правильным питанием
pH кала
Это показатель определяет уровень кислотности и щелочности в микрофлоре кишечника. Любое отклонение от стандарта в анализе кала у детей свидетельствует о наличии воспалительных процессов, а также может указывать на наличие паразитарных болезней, вирусов или бактерий.
Как интерпретировать значение pH:
- pH до 5,5: кислая среда, не переносимость молочных продуктов, реакция организма на лактозу;
- pH от 5,6 до 6,8: требуется обследование тонкой кишки;
- pH от 7,8 до 8: слабая работа кишечника;
- pH от 8,1 до 8,5: колиты, запоры, дисфункция поджелудочной железы;
- pH более 8,5: нарушение пищеварительной системы или диспепсия, преобладание щелочной среды.




































